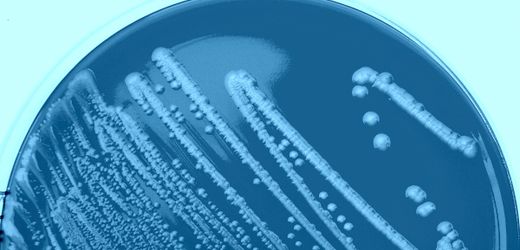

Ehec: Was den Ausbruch in Mecklenburg-Vorpommern so besonders macht
Dass sich die Ehec-Fälle in Mecklenburg-Vorpommern so stark häuften, alarmierte die Behörden. Der aktuelle Ausbruch ist zwar deutlich kleiner, als er anfangs wirkte. Der dahintersteckende Erreger jedoch ist besonders virulent.
Dass sich die Ehec-Fälle in Mecklenburg-Vorpommern so stark häuften, alarmierte die Behörden. Der aktuelle Ausbruch ist zwar deutlich kleiner, als er anfangs wirkte. Der dahintersteckende Erreger jedoch ist besonders virulent. Weiterlesen





